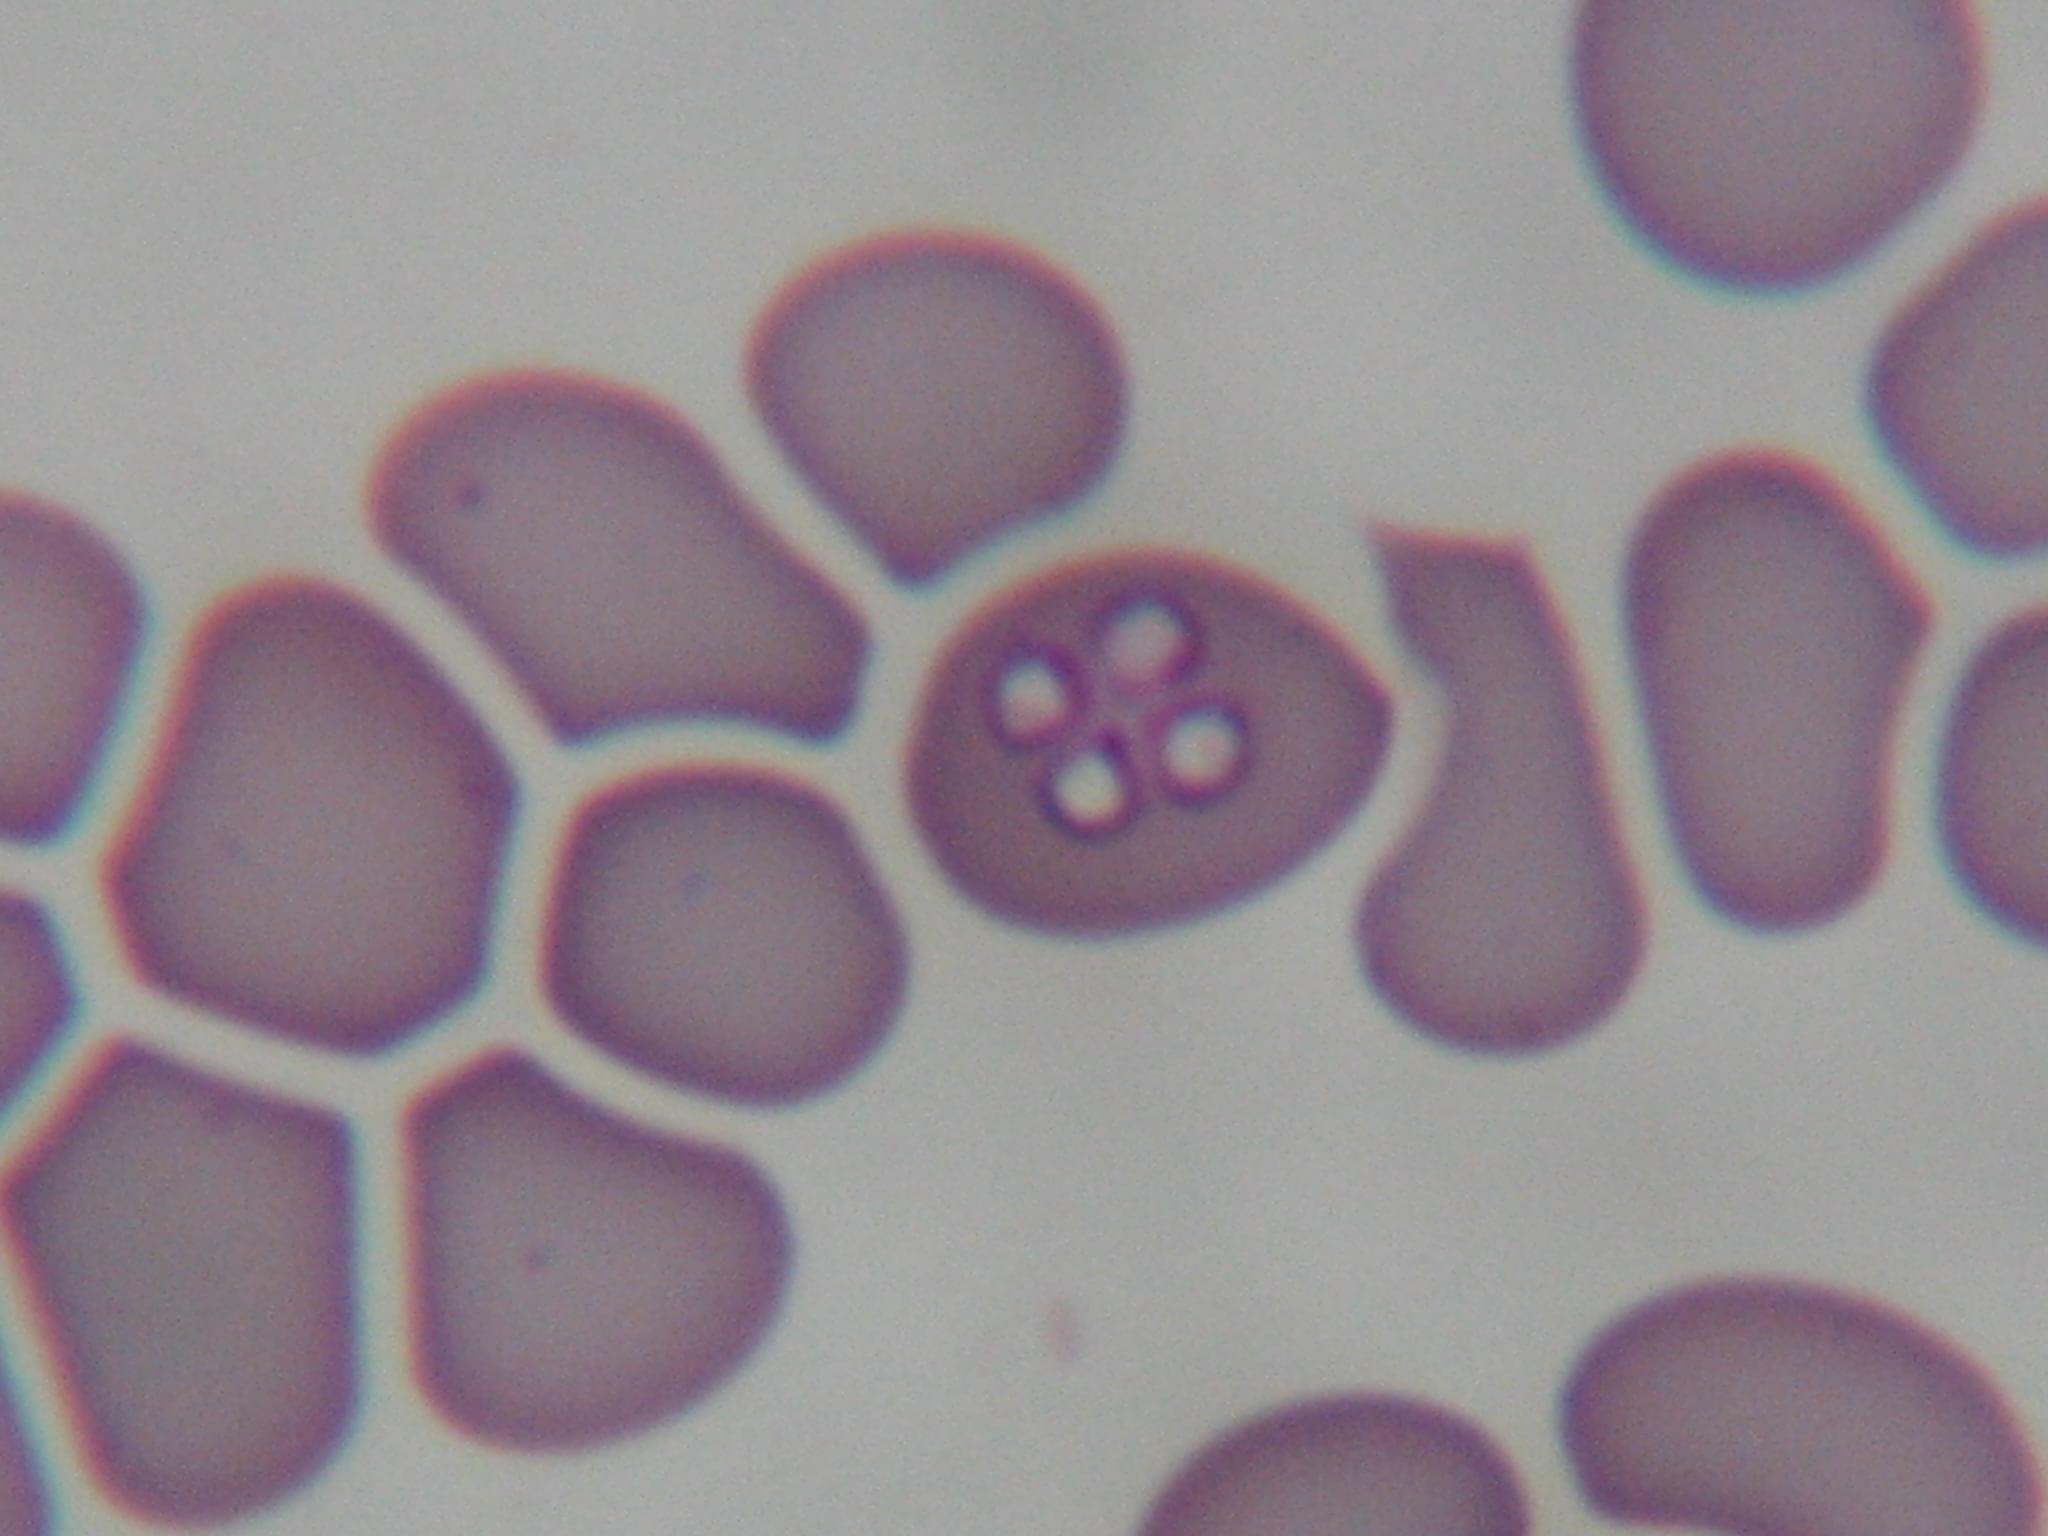

Laboratoire d'analyses vétérinaires
Notre Clinique Vétérinaire dispose d’un laboratoire d’analyses performant équipé d’appareils sophistiqués et de matériel nous permettant de réaliser sur place et en quelques minutes seulement les analyses de sang (hématologie, biochimie, ionogramme, endocrinologie, temps de coagulation), d’urines et de selles.
Par exemple, sur le sang, il nous est possible d’effectuer des numérations des globules et de doser divers paramètres chimiques courants en moins de 2 minutes.
Frottis de globules rouges parasités (piroplasmose du chien)
Des analyses sont proposées et réalisées dès que nous jugeons que l’état de santé de votre animal le justifie (en cas d'urgence vitale, pour préciser un diagnostic, pour juger de la gravité d’un cas ou parfois, tout simplement, pour rassurer…). Les analyses peuvent aussi s’intégrer à un bilan de santé (pré-opératoire, gériatrie…), à un tarif forfaitaire.
Nous effectuons aussi divers tests de dépistage de maladies infectieuses ou parasitaires, ainsi que les antibiogrammes.
Certaines analyses, peuvent être sous-traitées auprès de notre réseau de partenaires :
- Ecoles Nationales Vétérinaires
- Laboratoires de génétique
- …
Découvrez en images notre laboratoire partenaire : Idexx Alfort...


















